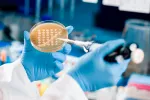
Wolbachia, la bacteria que evita que los mosquitos transmitan el zika

El cribado infantil puede prevenir ataques al corazón

El cribado infantil permitiría identificar a los individuos con más probabilidades de sufrir un ataque al corazón a una edad temprana.
04/11/2016
Realizar un cribado a los niños de 1 a 2 años de edad aprovechando el momento en el que se les administran sus vacunas de rutina, permitiría detectar las cardiopatías hereditarias y, de esta forma, establecer un tratamiento adecuado con el que se podrían prevenir ataques cardíacos al llegar a la adultez, según señala un estudio clínico que han dirigido investigadores de la Universidad Queen Mary de Londres (QMUL), en Reino Unido, en el que han participado más de 10.000 menores.
La hipercolesterolemia familiar (HF), una patología hereditaria que se caracteriza por elevados niveles de colesterol, puede multiplicar por diez el riesgo de sufrir un ataque al corazón antes de los 40 años de edad, por lo que diagnosticar esta enfermedad precozmente, y establecer un tratamiento adecuado, es muy importante para evitar graves problemas de salud a los afectados.
La hipercolesterolemia familiar (HF) puede multiplicar por diez el riesgo de sufrir un ataque al corazón antes de los 40 años de edad
En el estudio clínico, en el que se analizaron el colesterol y las mutaciones FH en los niños, los investigadores observaron que la prevalencia de dichas mutaciones era de aproximadamente 1 en 270, mientras que hasta ahora solo se informaba 1 en 500. Debido a que el trastorno es hereditario, el cribado permite que se detecte la patología tanto en el hijo, como en el progenitor afectado, y los investigadores identificaron una persona con riesgo alto de ataque cardiaco por cada 125 sujetos examinados.
El tratamiento médico, en el que se incluyen estatinas, puede iniciarse en los niños en la adolescencia y, junto a una dieta adecuada y otros hábitos saludables, como evitar el tabaco o practicar ejercicio, puede prevenir los ataques cardíacos y otras complicaciones de la hipercolesterolemia. Como ha explicado el principal investigador, el profesor David Wald, este cribado padre-hijo es la única forma de detección precoz que podría abarcar a toda la población, e identificar a aquellos individuos con más probabilidades de sufrir un ataque al corazón a una edad temprana.
Actualizado: 1 de abril de 2019